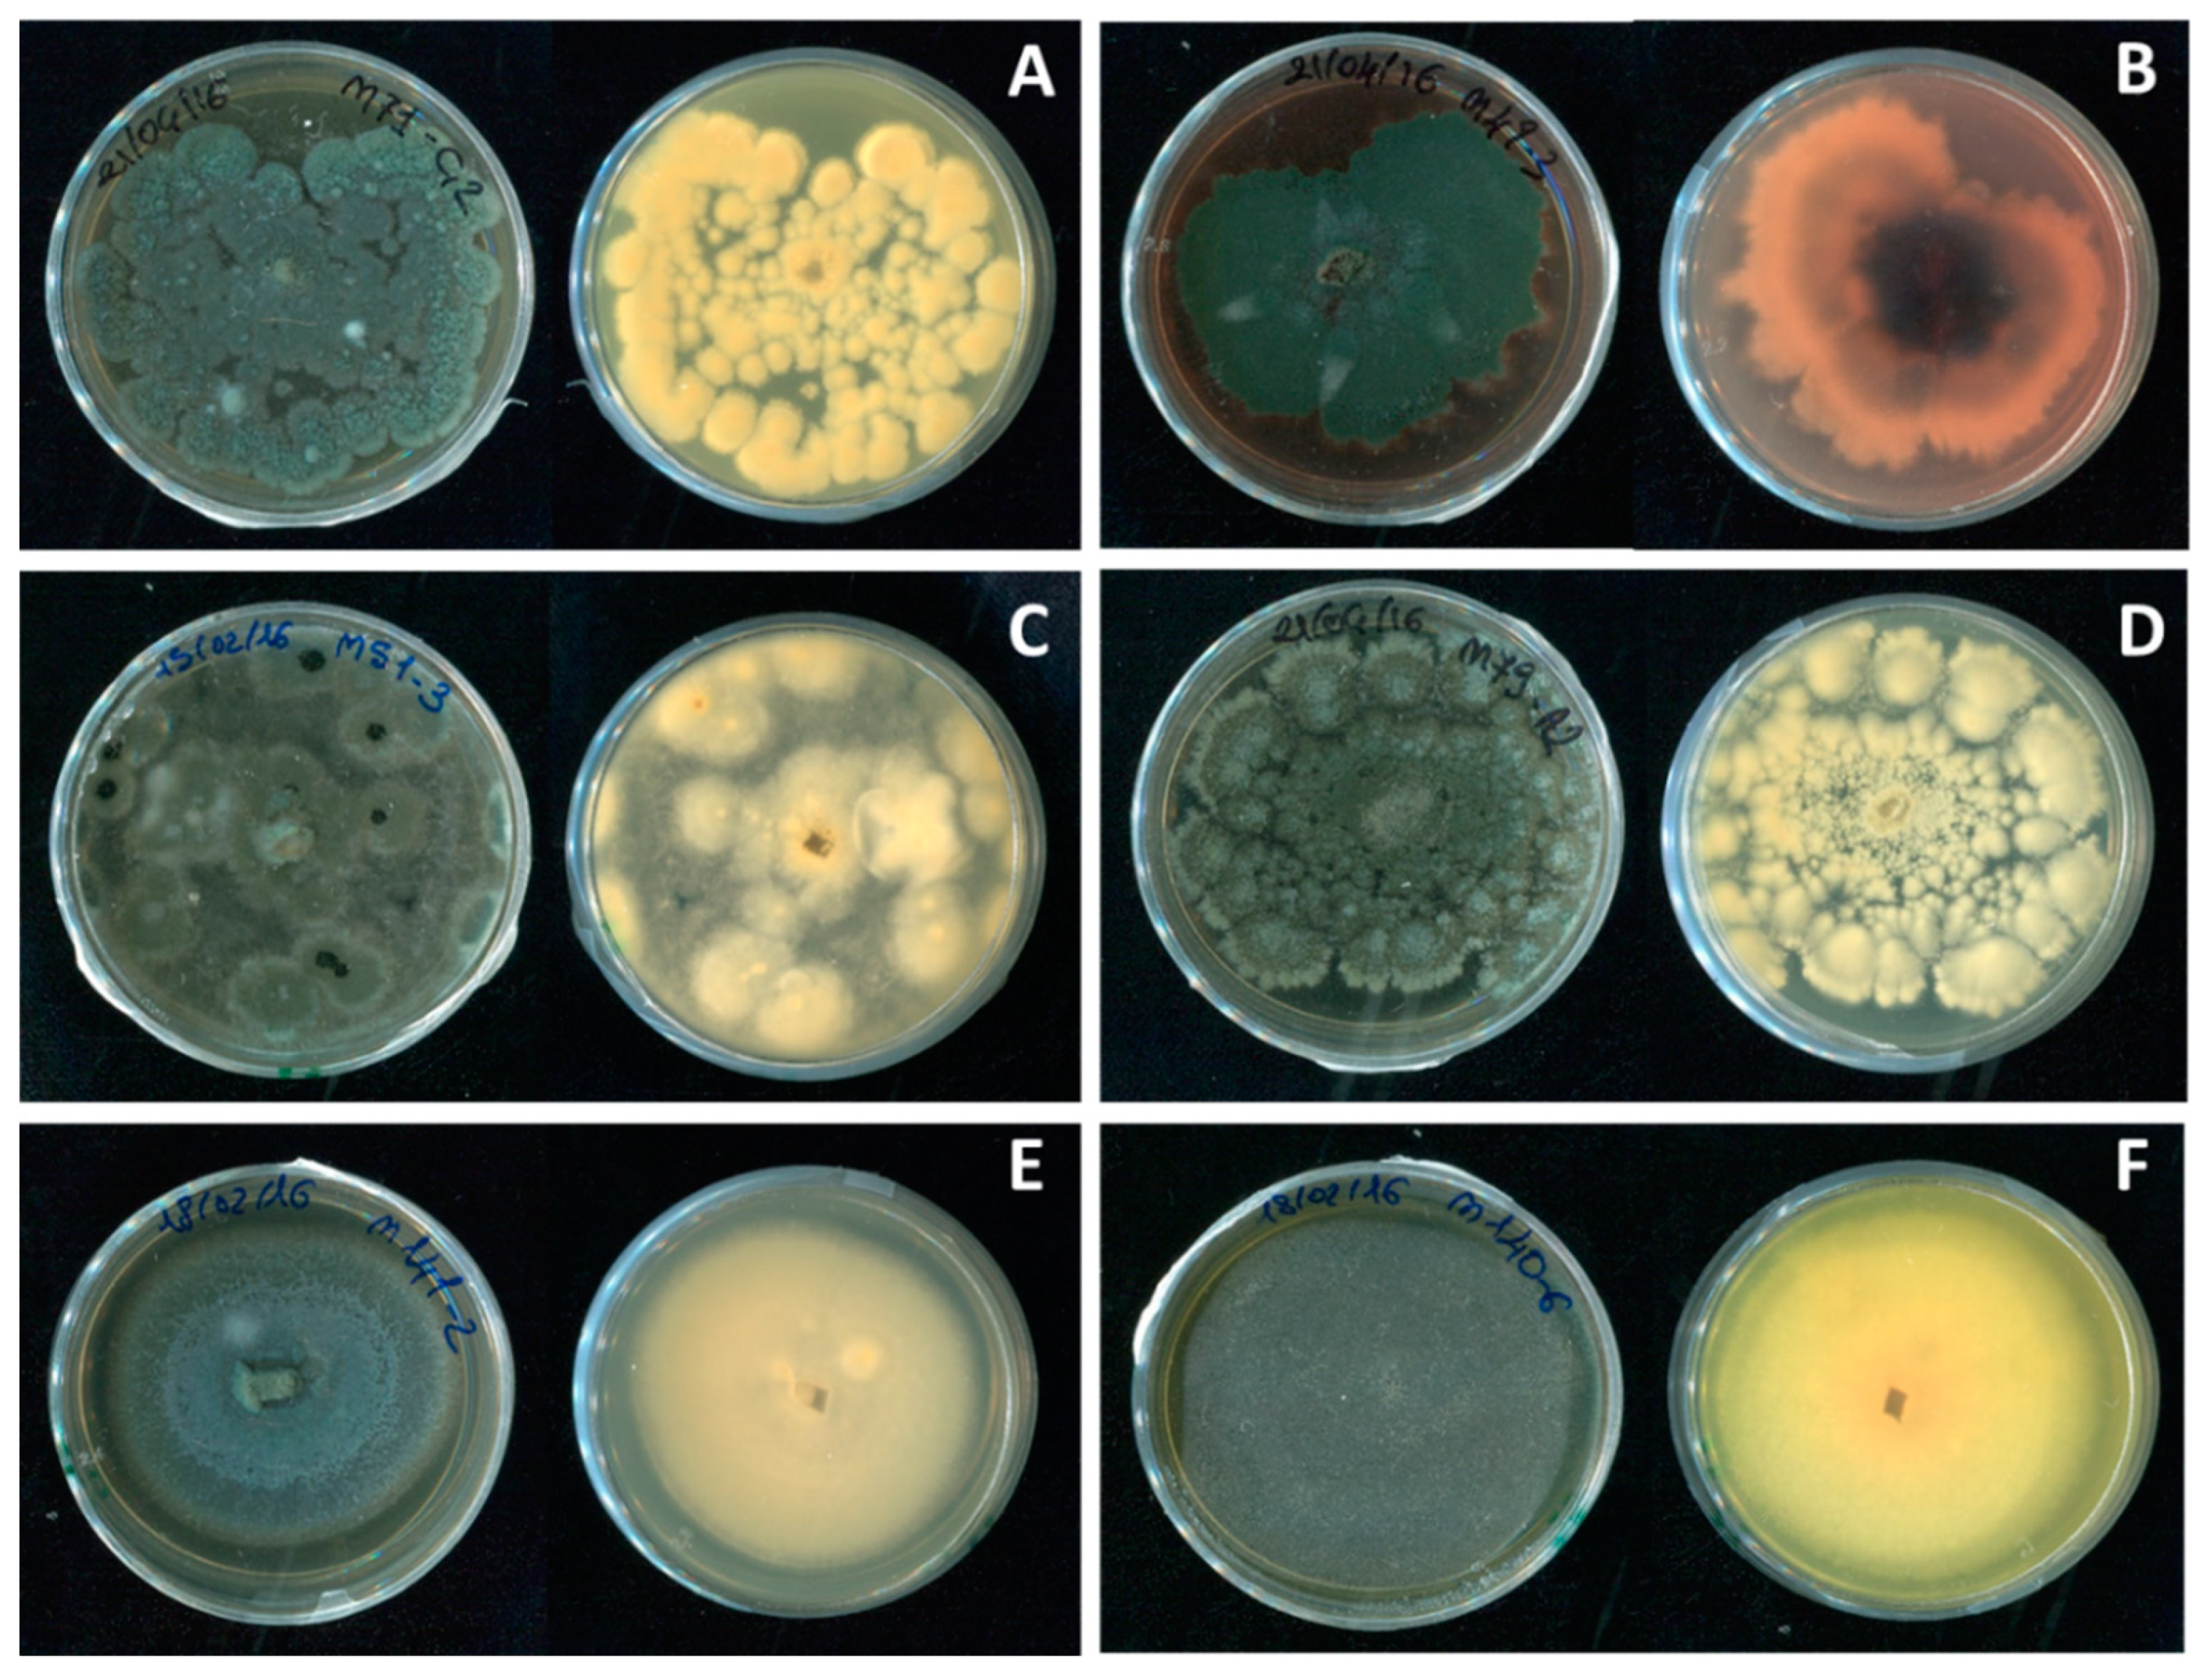
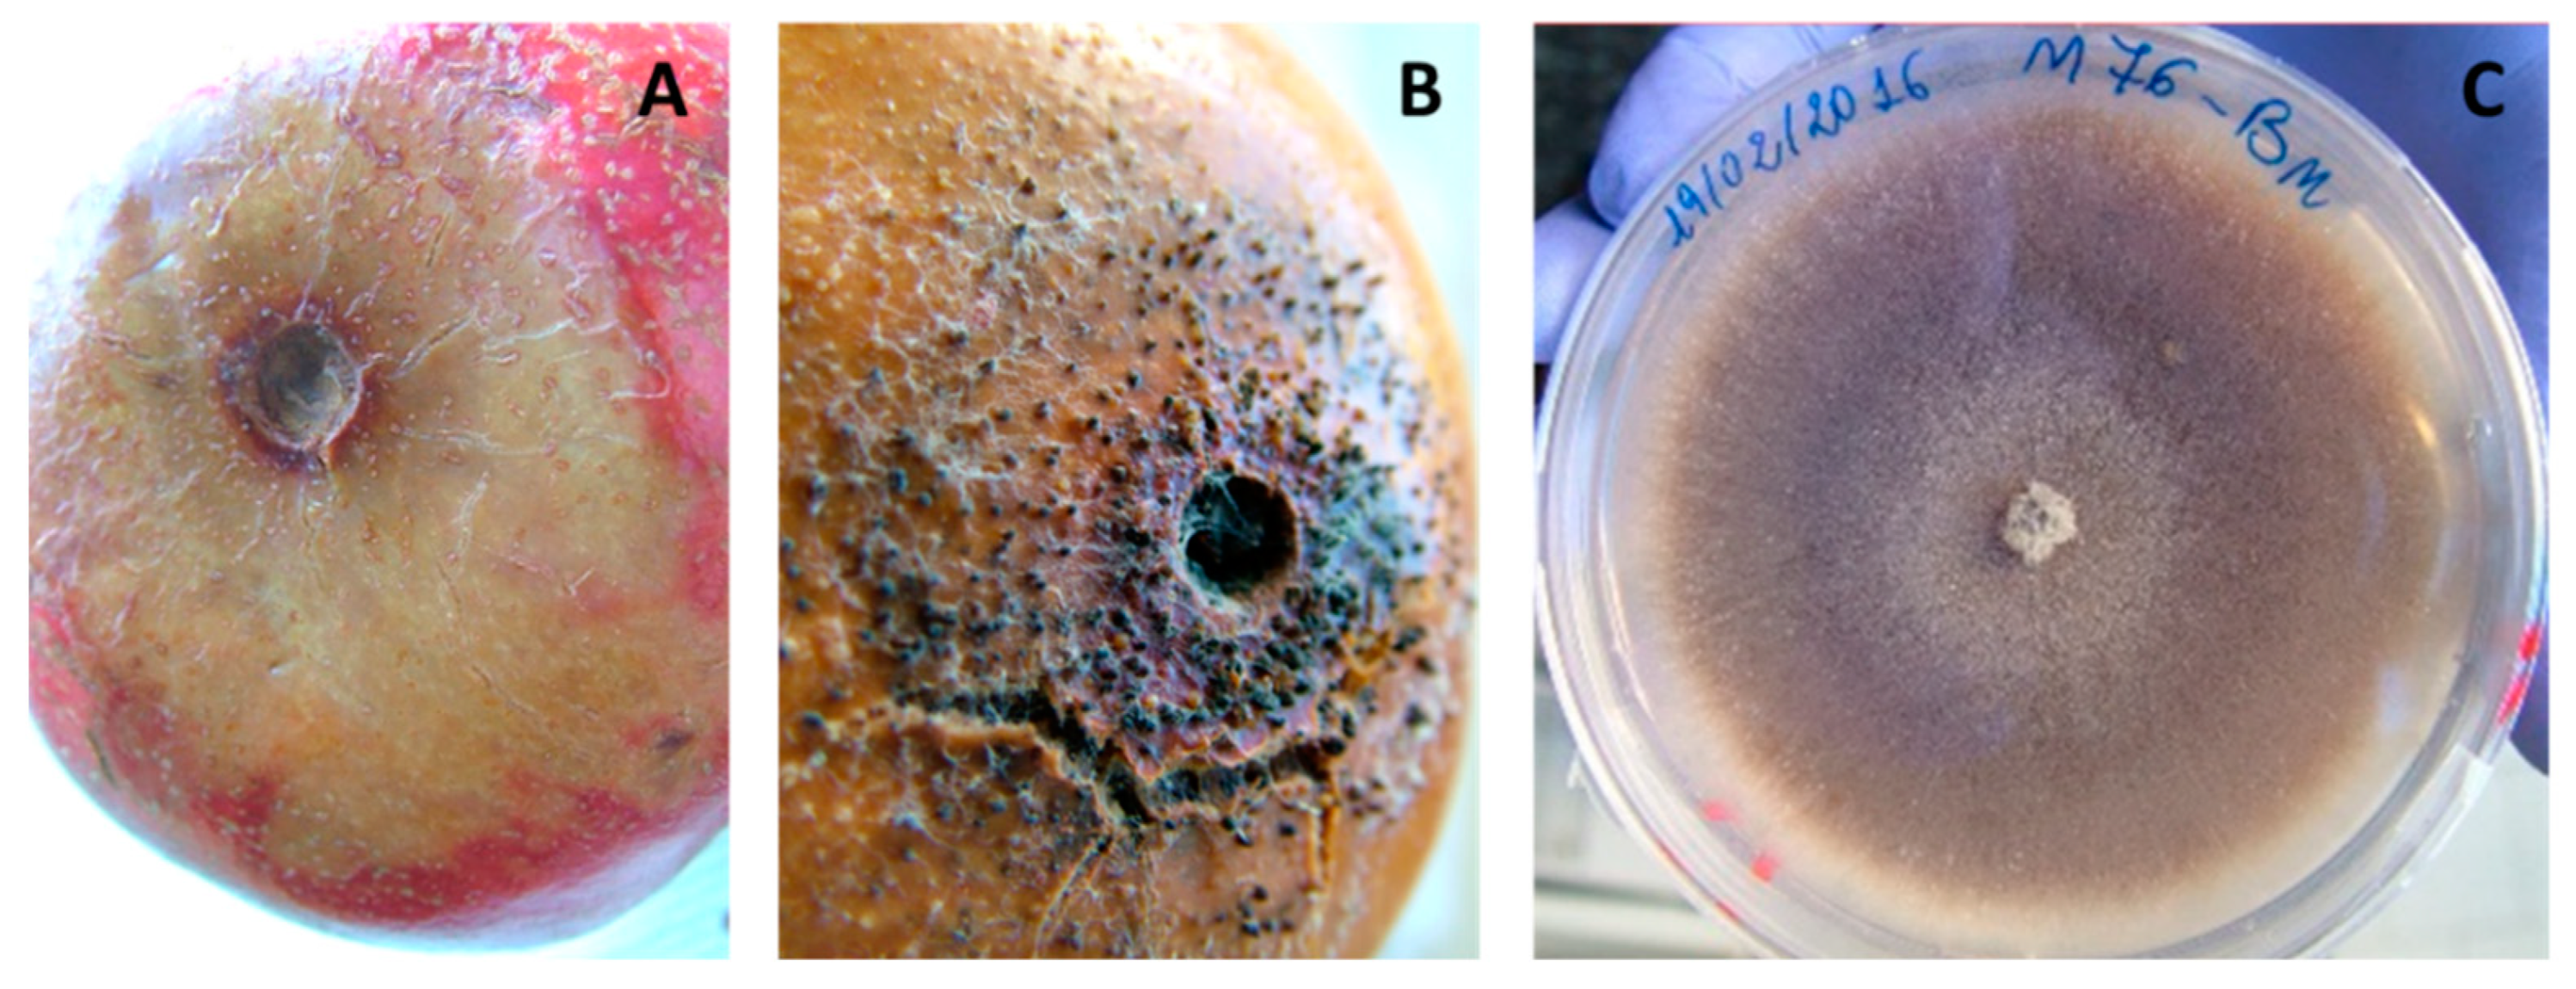

Postharvest Rot of Pomegranate Fruit in Southern Italy: Characterization of the Main Pathogens
Abstract
1. Introduction
2. Materials and Methods
2.1. Isolate Collection
2.1.1. Morphological Identification
2.1.2. Molecular Identification
3. Results
Fungal Pathogens of Pomegranate Fruit
4. Discussion
5. Conclusions
Supplementary Materials
Author Contributions
Funding
Institutional Review Board Statement
Informed Consent Statement
Data Availability Statement
Acknowledgments
Conflicts of Interest
References
- Holland, D.; Hatib, K.; Bar-Ya’akov, I. Pomegranate: Botany, horticulture, breeding. Hortic. Rev. 2009, 35, 127–192. [Google Scholar]
- Teixeira da Silva, J.A.; Rana, T.S.; Narzary, D.; Verma, N.; Mersham, D.T.; Ranade, S.A. Pomegranate biology and biotechnology: A review. Sci. Hortic. 2013, 160, 85–107. [Google Scholar] [CrossRef]
- Pienaar, L. The Economic Contribution of South Africa’s Pomegranate Industry. 2021. Available online: https://www.sapomegranate.co.za/wp-content/uploads/2021/05/PomegranteReport_2021F.pdf (accessed on 20 September 2021).
- Kahramanoğlu, I. Trends in pomegranate sector: Production, postharvest handling and marketing. Int. J. Agric. For. Life Sci. 2019, 3, 239–246. [Google Scholar]
- Özgüven, I.A.; Gültekin, U.; Gözlekçi, S.; Yilmaz, I.; Yilmaz, C.; Küçük, E.; Imrak, B.; Korkmaz, C. A review of the economics and the marketing of the pomegranate industry in Turkey. Acta Hortic. 2015, 1089, 221–228. [Google Scholar] [CrossRef]
- Stiletto, A.; Trestini, S. Factors behind consumers’ choices for healthy fruits: A review of pomegranate and its food derivatives. Agric. Food Econ. 2021, 9, 1–27. [Google Scholar] [CrossRef]
- Adiletta, G.; Petriccione, M.; Liguori, L.; Pizzolongo, F.; Romano, R.; Di Matteo, M. Study of pomological traits and physico-chemical quality of pomegranate (Punica granatum L.) genotypes grown in Italy. Eur. Food Res. Technol. 2018, 244, 1427–1438. [Google Scholar] [CrossRef]
- Zehra, T.; Ahmed, S.; Zehra, S. Review of characteristic components, traditional and pharmacological properties of Punica granatum. RADS J. Pharm. Pharm. Sci. 2019, 7, 39–52. [Google Scholar]
- Rymon, D. The prices in Europe of pomegranates and arils. In II International Symposium on the Pomegranate, CIHEAM Options Méditerranéennes: Série A; Séminaires Méditerranéens: Zaragoza, Spain, 2012; pp. 37–41. [Google Scholar]
- Murthy, D.S.; Gajanana, T.M.; Sudha, M.; Dakshinamoorthy, V. Marketing and post-harvest losses in fruits: Its implications on availability and economy. Marketing 2009, 64, 1–17. [Google Scholar]
- Shanabhoga, M.B.; Suresha, S.V.; Varadaraju, G.M.; Dechamma, S. Marketing of pomegranate by the growers using public and private extension service. Res. J. Agric. Sci. 2017, 8, 705–707. [Google Scholar]
- Opara, I.K.; Fawole, O.A.; Kelly, C.; Opara, U.L. Quantification of on-farm pomegranate fruit postharvest losses and waste, and implications on sustainability indicators: South African case study. Sustainability 2021, 13, 5168. [Google Scholar] [CrossRef]
- Opara, I.K.; Fawole, O.A.; Opara, U.L. Postharvest losses of pomegranate fruit at the packhouse and implications for sustainability indicators. Sustainability 2021, 13, 5187. [Google Scholar] [CrossRef]
- Matityahu, I.; Marciano, P.; Holland, D.; Ben-Arie, R.; Amir, R. Differential effects of regular and controlled atmosphere storage on the quality of three cultivars of pomegranate (Punica granatum L.). Postharvest Biol. Technol. 2016, 115, 132–141. [Google Scholar] [CrossRef]
- Bolel, H.; Koyuncu, M.A.; Erbaş, D.E.R.Y.A. The combined effect of controlled atmosphere with ozone and prochloraz treatment on storage life and quality of pomegranate cv. Hicaznar. Akad. Ziraat Derg. 2019, 8, 195–202. [Google Scholar] [CrossRef]
- Palou, L.; Taberner, V.; Guardado, A.; del Rio, M.A.; Monstesinos-Herrero, C. Incidence and etiology of postharvest fungal diseases of pomegranate (Punica granatum cv. Mollar de Elche) in Spain. Phytopathol. Mediterr. 2013, 52, 478–489. [Google Scholar]
- Thomidis, T. Fruit rots of pomegranate (cv. Wonderful) in Greece. Australas. J. Plant Pathol. 2014, 43, 583–588. [Google Scholar] [CrossRef]
- Thomidis, T. Pathogenicity and characterization of Coniella granati causing pomegranate diseases in Greece. Eur. J. Plant Pathol. 2014, 141, 45–50. [Google Scholar] [CrossRef]
- Kanetis, L.; Testempasis, S.; Goulas, V.; Samuel, S.; Myresiotis, C.; Karaoglanidis, G.S. Identification and mycotoxigenic capacity of fungi associated with pre and postharvest fruit rots of pomegranates in Greece and Cyprus. Int. J. Food Microbiol. 2015, 208, 84–92. [Google Scholar] [CrossRef]
- Munhuweyi, K.; Lennox, C.L.; Meitz-Hopkins, J.C.; Caleb, O.J.; Opara, U.L. Major diseases of pomegranate (Punica granatum L.), their causes and management—A review. Sci. Hortic. 2016, 211, 126–139. [Google Scholar] [CrossRef]
- Barnett, H.L.; Hunter, B.B. Illustrated Genera of Imperfect Fungi, 4th ed.; APS Press: St. Paul, MN, USA, 1998. [Google Scholar]
- Simmons, E.G. Alternaria: An identification manual. In Fully Illustrated and with Catalogue Raisonné; CBS Biodiversity Centre: Utrecht, The Netherlands, 2007; Volume 1796–2007. [Google Scholar]
- Samson, R.A.; Visagie, C.M.; Houbraken, J.; Hong, S.-B.; Hubka, V.; Klaassen, C.H.W.; Perrone, G.; Seifert, K.A.; Susca, A.; Tanney, J.B.; et al. Phylogeny, identification and nomenclature of the genus Aspergillus. Stud. Mycol. 2014, 78, 141–173. [Google Scholar] [CrossRef]
- Visagie, C.M.; Houbraken, J.; Frisvad, J.C.; Hong, S.-B.; Klaassen, C.H.W.; Perrone, G.; Seifert, K.A.; Varga, J.; Yaguchi, T.; Samson, R.A. Identification and nomenclature of the genus Penicillium. Stud. Mycol. 2014, 78, 343–371. [Google Scholar] [CrossRef]
- Sanzani, S.M.; Schena, L.; De Cicco, V.; Ippolito, A. Early detection of Botrytis cinerea latent infections as a tool to improve postharvest quality of table grapes. Postharvest Biol. Technol. 2012, 68, 64–71. [Google Scholar] [CrossRef]
- Mincuzzi, A.; Ippolito, A.; Montemurro, C.; Sanzani, S.M. Characterization of Penicillium s.s. and Aspergillus sect. nigri causing postharvest rots of pomegranate fruit in Southern Italy. Int. J. Food Microbiol. 2020, 314, 108389. [Google Scholar] [CrossRef] [PubMed]
- Garganese, F.; Ippolito, A.; di Rienzo, V.; Lotti, C.; Montemurro, C.; Sanzani, S.M. A new high-resolution melting assay for genotyping Alternaria species causing citrus brown spot. J. Sci. Food Agric. 2018, 98, 4578–4583. [Google Scholar] [CrossRef] [PubMed]
- Mincuzzi, A.; Garganese, F.; Ippolito, A.; Sanzani, S.M. First report of Pilidiella granati causing postharvest fruit rot on pomegranate in southern Italy. J. Plant Pathol. 2016, 98, 377. [Google Scholar]
- Mincuzzi, A.; Ippolito, A.; Sanzani, S.M. First report of Colletotrichum acutatum sensu stricto causing postharvest rot on pomegranate fruit in Italy. J. Plant Pathol. 2017, 99, 818. [Google Scholar] [CrossRef]
- Mincuzzi, A.; Sanzani, S.M.; Garganese, F.; Ligorio, A.; Ippolito, A. First report of Cytospora punicae causing fruit rot on pomegranate in Italy. J. Plant Pathol. 2017, 99, 302. [Google Scholar] [CrossRef]
- Bardas, G.A.; Tzelepis, G.D.; Lotos, L.; Karaoglanidis, G.S. First report of Penicillium glabrum causing fruit rot of pomegranate (Punica granatum) in Greece. Plant Dis. 2009, 93, 1347. [Google Scholar] [CrossRef]
- Palou, L.; Guardado, A.; Montesinos-Herrero, C. First report of Penicillium spp. and Coniella granati causing postharvest fruit rot of pomegranate in Spain. New Dis. Rep. 2010, 22, 21. [Google Scholar] [CrossRef]
- Hammerschmidt, L.; Wray, V.; Lin, W.; Kamilova, E.; Proksch, P.; Aly, A.H. New styrylpyrones from the fungal endophyte Penicillium glabrum isolated from Punica granatum. Phytochem. Lett. 2012, 5, 600–603. [Google Scholar] [CrossRef]
- Labuda, R.; EHudec Piecková, K.; Mezey, J.; Bohovič, R.; Mátéová, S.; Lukáč, S.S. Penicillium implicatum causes a destructive rot of pomegranate fruits. Mycopathologia 2004, 157, 217–223. [Google Scholar] [CrossRef]
- Spadaro, D.; Amatulli, M.T.; Garibaldi, A.; Gullino, M.L. First report of Penicillium glabrum causing a postharvest fruit rot of pomegranate (Punica granatum) in the Piedmont Region of Italy. Plant Dis. 2010, 94, 1066. [Google Scholar] [CrossRef] [PubMed]
- Quaglia, M.; Moretti, C.; Cerri, M.; Linoci, G.; Cappelletti, G.; Urbani, S.; Taticchi, A. Effect of extracts of wastewater from olive milling in postharvest treatments of pomegranate fruit decay caused by Penicillium adametzioides. Postharvest Biol. Technol. 2016, 118, 26–34. [Google Scholar] [CrossRef]
- Ezra, D.; Kirshner, B.; Hershcovich, M.; Shtienberg, D.; Kosto, I. Heart rot of pomegranate: Disease etiology and the events leading to development of symptoms. Plant Dis. 2015, 99, 496–501. [Google Scholar] [CrossRef] [PubMed]
- Ahmed, H.; Strub, C.; Hilaire, F.; Schorr-Galindo, S. First report: Penicillium adametzioides, a potential biocontrol agent for ochratoxin-producing fungus in grapes, resulting from natural product pre-harvest treatment. Food Control 2015, 51, 23–30. [Google Scholar] [CrossRef]
- Mincuzzi, A.; Sanzani, S.M.; Ippolito, A. (Department of Soil, Plant, and Food Sciences, University of Bari Aldo Moro, Via Amendola 165/A, 70126 Bari, Italy) Unpublished work concerning pathogenicity assays of postharvest fungi of pomegranate fruit, 2016.
- Rand, T.G.; Giles, S.; Flemming, J.; Miller, J.D.; Puniani, E. Inflammatory and cytotoxic responses in mouse lungs exposed to purified toxins from building isolated Penicillium brevicompactum Dierckx and P. chrysogenum Thom. Toxicol. Sci. 2005, 87, 213–222. [Google Scholar] [CrossRef] [PubMed]
- Visagie, C.M.; Seifert, K.A.; Houbraken, J.; Samson, R.A.; Jacobs, K. A phylogenetic revision of Penicillium sect Exilicaulis, including nine new species from fynbos in South Africa. IMA Fungus 2016, 7, 75–117. [Google Scholar] [CrossRef]
- Houbraken, J.; Frisvad, J.C.; Samson, R.A. Taxonomy of Penicillium citrinum and related species. Fungal Divers. 2010, 44, 117–133. [Google Scholar] [CrossRef]
- Visagie, C.M.; Houbraken, J.; Rodriques, C.; Pereira, C.S.; Dijksterhuis, J.; Seifert, K.A.; Jacobs, K.; Samson, R.A. Five new Penicillium species in section Sclerotiora: A tribute to the Dutch Royal family. Pers. Mol. Phylogeny Evol. Fungi 2013, 31, 42. [Google Scholar] [CrossRef]
- Rivera, K.G.; Seifert, K.A. A taxonomic and phylogenetic revision of the Penicillium sclerotiorum complex. Stud. Mycol. 2011, 70, 139–158. [Google Scholar] [CrossRef]
- Houbraken, J.; Frisvad, J.C.; Samson, R.A. Taxonomy of Penicillium section Citrina. Stud. Mycol. 2011, 70, 53–138. [Google Scholar] [CrossRef]
- Pfohl-Leszkowicz, A.; Manderville, R.A. Ochratoxin A: An overview on toxicity and carcinogenicity in animals and humans. Mol. Nutr. Food Res. 2007, 51, 61–99. [Google Scholar] [CrossRef] [PubMed]
- Pascual-Ahuir, A.; Vanacloig-Pedros, E.; Proft, M. Toxicity mechanisms of the food contaminant citrinin: Application of a quantitative yeast model. Nutrients 2014, 6, 2077–2087. [Google Scholar] [CrossRef] [PubMed]
- Khokhar, I.; Bajwa, R.; Nasim, G. New report of Penicillium implicatum causing a postharvest rot of pomegranate fruit in Pakistan. Australas. Plant Pathol. 2013, 8, 39–41. [Google Scholar] [CrossRef][Green Version]
- Mincuzzi, A.; Sanzani, S.M.; Garganese, F.; Ligorio, A.; Ippolito, A. First report of Talaromyces albobiverticillius causing postharvest fruit rot on pomegranate in Italy. J. Plant Pathol. 2017, 99, 303. [Google Scholar] [CrossRef]
- Frisvad, J.C.; Yilmaz, N.; Thrane, U.; Rasmussen, K.B.; Houbraken, J.; Samson, R.A. Talaromyces atroroseus, a new species efficiently producing industrially relevant red pigments. PLoS ONE 2013, 8, e84102. [Google Scholar] [CrossRef]
- Venkatachalam, M.; Zelena, M.; Cacciola, F.; Ceslova, L.; Girard-Valenciennes, E.; Clerc, P.; Dugo, P.; Mondello, L.; Fouillaud, M.; Rotondo, A.; et al. Partial characterization of the pigments produced by the marine-derived fungus Talaromyces albobiverticillius 30548. Towards a new fungal red colorant for the food industry. J. Food Compos. Anal. 2018, 67, 38–47. [Google Scholar] [CrossRef]
- Schafhauser, T.; Kirchner, N.; Kulik, A.; Huijbers, M.M.; Flor, L.; Caradec, T.; Fewer, D.P.; Gross, H.; Jacques, P.; Jahn, L.; et al. The cyclochlorotine mycotoxin is produced by the nonribosomal peptide synthetase CctN in Talaromyces islandicus (‘Penicillium islandicum’). Environ. Microbiol. 2016, 18, 3728–3741. [Google Scholar] [CrossRef]
- Aloi, F.; Riolo, M.; Sanzani, S.M.; Mincuzzi, A.; Ippolito, A.; Siciliano, I.; Pane, A.; Gullino, M.L.; Cacciola, S.O. Characterization of Alternaria species associated with heart rot of pomegranate fruit. J. Fungi 2021, 7, 172. [Google Scholar] [CrossRef]
- Luo, Y.; Hou, L.; Förster, H.; Pryor, B.; Adaskaveg, J.E. Identification of Alternaria species causing heart rot of pomegranates in California. Plant Dis. 2017, 101, 421–427. [Google Scholar] [CrossRef]
- Gat, T.; Liarzi, O.; Skovorodnikova, Y.; Ezra, D. Characterization of Alternaria alternata causing black spot disease of pomegranate in Israel using a molecular marker. Plant Dis. 2012, 96, 1513–1518. [Google Scholar] [CrossRef]
- Puckett, R.; Morgan, D.; Luna, M.; Wilkins, E.; Medrano, N.; Themis, J. Understanding Black Heart and Botrytis Gray Mold of Pomegranate and Management of These Diseases. 2013. Available online: http://ir4.rutgers.edu/Fooduse/PerfData/3797.pdf (accessed on 15 September 2018).
- Ezra, D.; Shulhani, R.; Bar Ya’akov, I.; Harel-Beja, R.; Holland, D.; Shtienberg, D. Factors affecting the response of pomegranate fruit to Alternaria alternata, the causal agent of Heart Rot. Plant Dis. 2019, 103, 315–323. [Google Scholar] [CrossRef] [PubMed]
- Kumar, A.; Chahal, T.S.; Singh, M.H.S.; Kaur, H.; Rawal, R. Studies of Alternaria black spot disease of pomegranate caused by Alternaria alternata in Punjab. J. Appl. Nat. Sci. 2017, 9, 156–161. [Google Scholar] [CrossRef]
- Oettl, S.; Bosello, M.; Marschall, K.; Gallmetzer, A.; Reyes-Domínguez, Y.; Kreutz, C.; Tollinger, M.; Robatscher, P.; Oberhuber, M. (3ξ, 4ξ, 5ξ, 6ξ, 7ξ, 11ξ)-3, 6-Dihydroxy-8-oxo-9-eremophilene-12-oic acid, a new phytotoxin of Alternaria alternata ssp. tenuissima isolates associated with fruit spots on apple (Malus× domestica Borkh.). J. Agric. Food Chem. 2021, 69, 14445–14458. [Google Scholar] [CrossRef]
- Elhariry, H.M.; Khiralla, G.M.; Gherbawy, Y.; Abd Elrahman, H. Natural occurrence of Alternaria toxins in pomegranate fruit and the influence of some technological processing on their levels in juice. Acta Aliment. 2016, 45, 380–389. [Google Scholar] [CrossRef]
- Chen, Y.; Shao, D.D.; Zhang, A.F.; Yang, X.; Zhou, M.G.; Xu, Y.L. First report of a fruit rot and twig blight on pomegranate (Punica granatum) caused by Coniella granati in Anhui Province of China. Plant Dis. 2014, 98, 695. [Google Scholar] [CrossRef]
- Çeliker, N.M.; Uysal, A.; Çetinel, B.; Poyraz, D. Crown rot on pomegranate caused by Coniella granati in Turkey. Australas. Plant Dis. Notes 2012, 7, 161–162. [Google Scholar] [CrossRef]
- Pollastro, S.; Dongiovanni, C.; Gerin, D.; Pollastro, P.; Fumarola, G.; De Miccolis Angelini, R.M.; Faretra, F. First report of Coniella granati as a causal agent of pomegranate crown rot in southern Italy. Plant Dis. 2016, 100, 1498. [Google Scholar] [CrossRef]
- Uysal, A.; Kurt, Ş.; Soylu, E.M.; Kara, M.; Soylu, S. Morphology, pathogenicity and management of Coniella fruit rot (Coniella granati) on pomegranate. Turk. J. Agric.-Food Sci. Technol. 2018, 6, 471–478. [Google Scholar] [CrossRef][Green Version]
- Barkai-Golan, R. Postharvest Diseases of Fruits and Vegetables: Development and Control; Elsevier: Amsterdam, The Netherlands, 2001. [Google Scholar]
- Lennox, C.L.; Mostert, L.; Venter, E.; Laubscher, W.; Meitz-Hopkins, J.C. First report of Coniella granati fruit rot and dieback on pomegranate in the western cape of South Africa. Plant Dis. 2018, 102, 821. [Google Scholar] [CrossRef]
- Michailides, T.J.; Puckett, R.; Morgan, D. Pomegranate decay caused by Coniella granati in California. Phytopathology 2010, 100, S83. [Google Scholar]
- Rossman, A.Y.; Farr, D.F.; Castlebury, L.A. A review of the phylogeny and biology of the Diaporthales. Mycoscience 2007, 48, 135–144. [Google Scholar] [CrossRef]
- Alvarez, L.V.; Groenewald, J.Z.; Crous, P.W. Revising the Schizoparmaceae: Coniella and its synonyms Coniella and Schizoparme. Stud. Mycol. 2016, 85, 1–34. [Google Scholar] [CrossRef] [PubMed]
- Mincuzzi, A.; Ippolito, A.; Brighenti, V.; Marchetti, L.; Benvenuti, S.; Ligorio, A.; Pellati, F.; Sanzani, S.M. The effect of polyphenols on pomegranate fruit susceptibility to Pilidiella granati provides insights into disease tolerance mechanisms. Molecules 2020, 25, 515. [Google Scholar] [CrossRef] [PubMed]
- Yang, X.; Gu, C.Y.; Abid, M.; Al-Attala, M.N.; Qin, G.H.; Xu, Y.L.; May Phyo, S.S.; Zhang, A.F.; Zang, H.I.; Chen, Y. Development of loop-mediated isothermal amplification assay for rapid diagnosis of pomegranate twig blight and crown rot disease caused by Coniella granati. Crop Prot. 2020, 135, 105190. [Google Scholar] [CrossRef]
- Testempasis, S.; Puckett, R.D.; Michailides, T.J.; Karaoglanidis, G.S. Genetic structure and fungicide resistance profile of Botrytis spp. populations causing postharvest gray mold of pomegranate fruit in Greece and California. Postharvest Biol. Technol. 2020, 170, 111319. [Google Scholar] [CrossRef]
- Selcuk, N.; Erkan, M. Changes in antioxidant activity and postharvest quality of sweet pomegranates cv. Hicrannar under modified atmosphere packaging. Postharvest Biol. Technol. 2014, 92, 29–36. [Google Scholar] [CrossRef]
- Yehia, H.M. Heart rot caused by Aspergillus niger through splitting in leathery skin of pomegranate fruit. Afr. J. Microbiol. Res. 2013, 7, 834–837. [Google Scholar] [CrossRef]
- Pala, H.; Tatli, A.; Yilmaz, C.; Özgüven, A.I. Important diseases of pomegranate fruit and control possibilities in Turkey. Acta Hortic. 2009, 818, 285–290. [Google Scholar] [CrossRef]
- Susca, A.; Proctor, R.H.; Morelli, M.; Haidukowski, M.; Gallo, A.; Logrieco, A.; Moretti, A. Variation in fumonisin and ochratoxin production associated with differences in biosynthetic gene content in Aspergillus niger and A. welwitschiae isolates from multiple crop and geographic origins. Front. Microbiol. 2016, 7, 1412. [Google Scholar] [CrossRef]
- Ferrara, M.; Gallo, A.; Perrone, G.; Magistà, D.; Baker, S.E. Comparative genomic analysis of ochratoxin A biosynthetic cluster in producing fungi: New evidence of a cyclase gene involvement. Front. Microbiol. 2020, 11, 3289. [Google Scholar] [CrossRef]
- Ferrara, M.; Gallo, A.; Cervini, C.; Gambacorta, L.; Solfrizzo, M.; Baker, S.E.; Perrone, G. Evidence of the involvement of a cyclase gene in the biosynthesis of ochratoxin A in Aspergillus carbonarius. Toxins 2021, 13, 892. [Google Scholar] [CrossRef] [PubMed]
- Arendse, E. Determining Optimum Storage Conditions for Pomegranate Fruit (cv. Wonderful). Master’s Thesis, Stellenbosch University, Stellenbosch, South Africa, 2014. [Google Scholar]
- Arendse, E.; Fawole, O.A.; Opara, U.L. Effects of postharvest handling and storage on physiological attributes and quality of pomegranate fruit (Punica granatum L.). Int. J. Postharvest Technol. Innov. 2015, 5, 13–31. [Google Scholar] [CrossRef]
- Thomidis, T.; Exadaktylou, E. Occurrence of a fruit spot disease of pomogranates caused by Colletotrichum gloeosporiodes (Penz) Sacc. in the Prefecture of Komotini, Greece. Plant Dis. 2011, 95, 872. [Google Scholar] [CrossRef] [PubMed]
- Nargund, V.B.; Jayalakshmi, K.; Benagi, V.I.; Byadgi, A.S.; Patil, R.V. Status and management of anthracnose of pomegranate in Karnataka State of India. Options Méditerranéennes Ser. A Semin. Mediterr. 2012, 103, 117–120. [Google Scholar]
- Jayalakshmi, K.; Nargund, V.B.; Raju, J.; Benagi, V.I. Cultural characteristics of Colletotrichum gloeosporioides (Penz.) Penz. and Sacc. causing anthracnose of pomegranate. BIOINFOLET-A Q. J. Life Sci. 2013, 10, 498–501. [Google Scholar]
- Rahimlou, S.; Babaeizad, V.; Sayari, M. First report of fruit spot of pomegranate caused by Colletotrichum gloeosporioides in Iran. J. Plant Pathol. 2014, 96, 605. [Google Scholar]
- Joshi, M.S.; Sawant, D.M.; Gaikwad, A.P. Isolate variations in Colletotrichum gloeosporioides infecting pomegranate. J. Plant Prot. Sci. 2014, 6, 21–26. [Google Scholar]
- Talhinhas, P.; Baroncelli, R. Colletotrichum species and complexes: Geographic distribution, host range and conservation status. Fungal Divers. 2021, 110, 109–198. [Google Scholar] [CrossRef]
- Silva-Cabral, J.R.A.; Batista, L.R.L.; de OCosta, J.F.; de MFerro, M.M.; Silva, S.J.C.; de ALima, G.S.; Assunção, I.P. First report of Colletotrichum tropicale causing anthracnose on pomegranate in Brazil. Plant Dis. 2019, 103, 583. [Google Scholar] [CrossRef]
- Xavier, K.V.; Kc, A.N.; Peres, N.A.; Deng, Z.; Castle, W.; Lovett, W.; Vallad, G.E. Characterization of Colletotrichum species causing anthracnose of pomegranate in the Southeastern United States. Plant Dis. 2019, 103, 2771–2780. [Google Scholar] [CrossRef]
- Palavouzis, S.C.; Tzamos, S.; Paplomatas, E.; Thomidis, T. First report of Cytospora punicae isolated from pomegranate plants with symptom of collar rot in northern Greece. J. Plant Pathol. 2015, 97, 216. [Google Scholar]
- Triki, M.A.; Gharbi, Y.; Cheffi, M.; Krid, S.; Rahma, T.; Hammami, I.; Hamdi, H.; Chaâbani, B.; Ali, H.B.; Gdoura, R. First report of Cytospora punicae associated with wood canker and branch dieback disease of pomegranate in Tunisia. J. Plant Pathol. 2015, 97, 550. [Google Scholar]
- Samouel, S.; Kanetis, L. First report of Cytospora punicae causing trunk canker of pomegranate (Punica granatum) in Cyprus. Plant Dis. 2016, 100, 222. [Google Scholar] [CrossRef]
- Venter, E.; Lennox, C.; Meitz, J.C. First report of Cytospora punicae causing post-harvest fruit rot on pomegranate in South Africa. Plant Dis. 2017, 101, 631. [Google Scholar] [CrossRef]
- Anastasi, A.; Spina, F.; Prigione, V.; Tigini, V.; Giansanti, P.; Varese, G.C. Scale-up of a bioprocess for textile wastewater treatment using Bjerkandera adusta. Bioresour. Technol. 2010, 101, 3067–3075. [Google Scholar] [CrossRef] [PubMed]
- Davila-Vazquez, G.; Tinoco, R.; Pickard, M.A.; Vazquez-Duhalt, R. Transformation of halogenated pesticides by versatile peroxidase from Bjerkandera adusta. Enzym. Microb. Technol. 2005, 36, 223–231. [Google Scholar] [CrossRef]
- Luangsa-ard, J.; Houbraken, J.; van Doorn, T.; Hong, S.-B.; Borman, A.M.; Hywel-Jones, N.L.; Samson, R.A. Purpureocillium, a new genus for the medically important Paecilomyces lilacinus. FEMS Microbiol. Lett. 2011, 321, 141–149. [Google Scholar] [CrossRef]
- Khan, Z.; Ahmad, S.; Al-Ghimlas, F.; Al-Mutairi, S.; Joseph, L.; Chandy, R.; Sutton, D.A.; Guarro, J. Purpureocillium lilacinum as a cause of cavitary pulmonary disease: A new clinical presentation and observations on atypical morphologic characteristics of the isolate. J. Clin. Microbiol. 2012, 50, 1800–1804. [Google Scholar] [CrossRef]
- Castillo Lopez, D.; Zhu-Salzman, K.; Ek-Ramos, M.J.; Sword, G.A. The entomopathogenic fungal endophytes Purpureocillium lilacinum (formerly Paecilomyces lilacinus) and Beauveria bassiana negatively affect cotton aphid reproduction under both greenhouse and field conditions. PLoS ONE 2014, 9, e103891. [Google Scholar] [CrossRef]
- Singh, S.; Pandey, R.K.; Goswami, B.K. Bio-control activity of Purpureocillium lilacinum strains in managing root-knot disease of tomato caused by Meloidogyne incognita. Biocontrol Sci. Technol. 2013, 23, 1469–1489. [Google Scholar] [CrossRef]

| Genus | Primer Name | Gene | Sequence (5′-3′) | Assay | Source |
|---|---|---|---|---|---|
| Botrytis | BcF | Intergenic spacer | TGTAATTTCAATGTGCAGAATCC | qPCR | [25] |
| BcR | TTGAAATGCGATTAATTGTTGC | ||||
| BcP | FAMCCGGTGAGCCCAGGTCACCT | ||||
| Penicillium sensu lato | Bt2a | β-tubulin | GGTAACCAAATCGGTGCTGCTTTC | PCR | [26] |
| Bt2b | ACCCTCAGTGTAGTGACCCTTGGC | ||||
| Penicillium sensu stricto | PPF1 | GAGCGYATGAACGTCTACTT | HRM | ||
| PPR1 | ACVAGGACGGCACGGGGAAC | ||||
| Talaromyces | TALF | CGAACAATCGAAAAGCAACC | PCR | ||
| TALR | TACTTTTTTCATGGTCCTTCG | ||||
| Aspergillus | CMD5 | Calmodulin | CCGAGTACAAGGARGCCTTC | PCR | |
| CMD6 | CCGATRGAGGTCATRACGTGG | ||||
| HRM-CMDF | ATAGGACAAGGATGGCGATG | HRM | |||
| HRM-CMDR | AGACTCGGAGGGGTTCTGGC | ||||
| Alternaria | OPA1–3-L | OPA1–3 | CAGGCCCTTCCAATCCAT | PCR | [27] |
| OPA1–3-R | AGGCCCTTCAAGCTCTCTTC | ||||
| HRMF | GCCCGATATCATCAGGGCAT | HRM | |||
| HRMR | ACTCCTACATCTCAAATGCCA | ||||
| Coniella | ITS5 | Internal transcribed spacer | GGAAGTAAAAGTCGTAACAAGG | PCR | [28] |
| ITS4 | TCCTCCGCTTATTGATATGC | ||||
| Colletotrichum | ITS5 | Internal transcribed spacer | GGAAGTAAAAGTCGTAACAAGG | PCR | [29] |
| ITS4 | TCCTCCGCTTATTGATATGC | ||||
| ACT512F | Actin | ATGTGCAAGGCCGGTTTCGC | |||
| ACT783R | TACGAGTCCTTCTGGCCCAT | ||||
| Bt2a | β-tubulin | GGTAACCAAATCGGTGCTGCTTTC | |||
| Bt2b | ACCCTCAGTGTAGTGACCCTTGGC | ||||
| GDF1 | Glyceraldehyde-3-phosphate dehydrogenase | GCCGTCAACGACCCCTTCATTGA | |||
| GDR1 | GGGTGGAGTCGTACTTGAGCATGT | ||||
| GSF1 | Glutamine synthetase | ATGGCCGAGTACATCTGG | |||
| GSR1 | GAACCGTCGAAGTTCCAC | ||||
| Cytospora | ITS1 | Internal transcribed spacer | TCCGTAGGTGAACCTGCGG | PCR | [30] |
| ITS2 | GCTGCGTTCTTCATCGATGC |
| Genus | Species | Incidence | Accession No. | Source |
|---|---|---|---|---|
| Botrytis | cinerea | 21% | N.A. | This study |
| Penicillium sensu stricto | adametzioides | 6% | MK895700; MK895701 | [26] |
| brevicompactum | 2% | MK895702; MK895703 | ||
| citrinum | <1% | MK895704 | ||
| glabrum | 13% | MK895705; MK895706 | ||
| jhonkrugii | 1% | MK895708; MK895709 | ||
| pagulum | <1% | MK895707 | ||
| Talaromyces | albobiverticillius | 3% | KY563698 | |
| Aspergillus | japonicus | <1% | MK919488 | |
| tubingensis | 5% | MK919489; MK919490 | ||
| uvarum | <1% | MK919493 | ||
| welwitschiae | 3% | MK919491; MK919492 | ||
| Alternaria | alternata | 23% | submitted | This study |
| arborescens | 1% | submitted | ||
| Coniella | granati | 15% | KU821701 | [28] |
| Colletotrichum | acutatum sensu stricto | 5% | MF581923; MF581920; MF581919; MF581921; MF581922 | [29] |
| Cytospora | punicae | <1% | KY496629 | [30] |
Publisher’s Note: MDPI stays neutral with regard to jurisdictional claims in published maps and institutional affiliations. |
© 2022 by the authors. Licensee MDPI, Basel, Switzerland. This article is an open access article distributed under the terms and conditions of the Creative Commons Attribution (CC BY) license (https://creativecommons.org/licenses/by/4.0/).
Share and Cite
Mincuzzi, A.; Sanzani, S.M.; Palou, L.; Ragni, M.; Ippolito, A. Postharvest Rot of Pomegranate Fruit in Southern Italy: Characterization of the Main Pathogens. J. Fungi 2022, 8, 475. https://doi.org/10.3390/jof8050475
Mincuzzi A, Sanzani SM, Palou L, Ragni M, Ippolito A. Postharvest Rot of Pomegranate Fruit in Southern Italy: Characterization of the Main Pathogens. Journal of Fungi. 2022; 8(5):475. https://doi.org/10.3390/jof8050475
Chicago/Turabian StyleMincuzzi, Annamaria, Simona Marianna Sanzani, Lluís Palou, Marco Ragni, and Antonio Ippolito. 2022. "Postharvest Rot of Pomegranate Fruit in Southern Italy: Characterization of the Main Pathogens" Journal of Fungi 8, no. 5: 475. https://doi.org/10.3390/jof8050475
APA StyleMincuzzi, A., Sanzani, S. M., Palou, L., Ragni, M., & Ippolito, A. (2022). Postharvest Rot of Pomegranate Fruit in Southern Italy: Characterization of the Main Pathogens. Journal of Fungi, 8(5), 475. https://doi.org/10.3390/jof8050475

